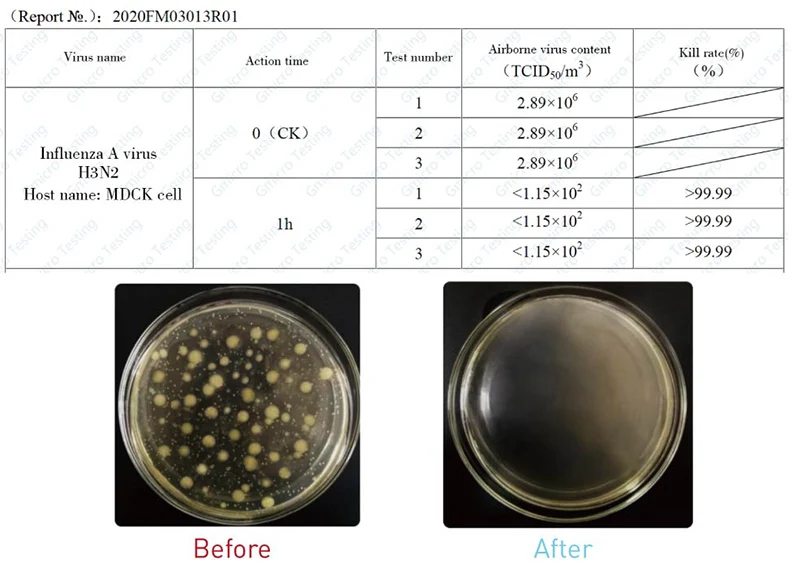

Share on (1600334696591):


Model | YL-UVS-72 |
Dimensions | 500 × 370 × 120 mm |
Serving Area | 80 m² |
Power Supply | 220 V [50/60Hz] |
UV-C Lamp Brand | PHILIPS |
UV Lamp Expected Service Life | 8000+ hours |
UV Lamp Timing Display | Yes |
UV Lamp Status Indicator | Yes |
Shell Material | Coated Sheet Steel |
● Pre-filter ● 36W UV-C Device x 2pcs ● Nano Titanium Module (Photocatalyst) | |
Control | Timer/ Remote |
Fan Motor | DC |
Safety Power Cut-off | Overheating Protection |
Installation Method | Floor Standing/ Table Top / Portable / Wall-mounted |

New products from manufacturers at wholesale prices